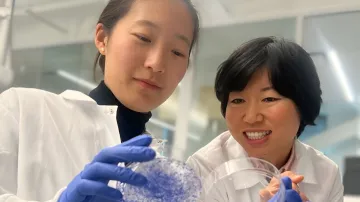
Profesorky Sung-nan Wang (vlevo) a Ling-jin Li (vpravo)

Po více než sto letech vývoje se do klinické praxe dostávají léčebné postupy, které využívají posílení vlastního imunitního systému člověka k boji s rakovinou. Tato metoda může nabídnout individuálně přizpůsobenou terapii, dlouhodobé ustoupení či vymizení příznaků a méně vedlejších účinků než chemoterapie či ozařování, píše stanice BBC. Vědci ale upozorňují, že navzdory pokračujícímu výzkumu je účinnost těchto postupů alespoň prozatím značně omezená.
Princip imunoterapie vychází z přirozené schopnosti imunitního systému rozpoznávat a ničit abnormální či poškozené buňky v těle. Nádorové tkáně však často dokážou této „kontrole“ uniknout. „Tělo má přirozenou schopnost detekovat a eliminovat struktury, které vypadají odlišně,“ vysvětlila Karen Knudsenová z Parkerova institutu pro imunoterapii rakoviny, americké neziskové organizace podporující rozvoj této disciplíny. Zhoubné bujení podle ní tuto obranu někdy obchází a splývá se zdravou tkání, takže zůstává skryté. Imunoterapie se snaží přimět obranný systém organismu, aby nádor rozpoznal a zničil.
Dvě cesty
Mezi nejrozšířenější imunoterapeutické postupy patří dva přístupy. První z nich, terapie CAR T-buněk, spočívá v odebrání vlastních obranných buněk pacienta, jejich úpravě v laboratoři a následném vrácení do organismu. Takto přeprogramované buňky pak dokáží lépe vyhledávat a napadat nádorovou tkáň. Tento postup se zatím používá hlavně u některých forem rakoviny krve.
Druhým přístupem jsou léky nazývané inhibitory kontrolních bodů imunitní reakce. Ty nezasahují přímo v buňkách, ale ovlivňují regulační mechanismy samotného imunitního systému, které za normálních okolností brání jeho přehnané aktivitě. Některé nádory tento systém dokáží zneužít a vyhnout se tak imunitní odpovědi. Léky tento blok odstraňují a umožňují organismu znovu zasáhnout. Za výzkum této skupiny léčiv vědci v roce 2018 získali Nobelovu cenu.
Léčba s velkým potenciálem. Ale i problémy
Účinnost imunoterapie však navzdory pokroku zůstává omezená. Pomáhá zhruba dvaceti až 40 procentům pacientů, u ostatních se účinek neprojeví vůbec nebo je jen částečný. Vědcům se rovněž nedaří zajistit účinnost terapie CAR T-buněk proti pevným nádorům. U omezování kontrolních bodů imunity varují lékaři před vedlejšími účinky, které mohou poškodit zdravé tkáně, například kůži, střeva, játra nebo srdce. Neexistuje žádná imunoterapie, která by fungovala u všech pacientů, upozornila onkoložka Samra Turajlicová z londýnského Institutu Francise Cricka. Podle ní hraje roli například struktura tumoru či vlastnosti imunitního systému.
Výzkum se proto zaměřuje na hledání způsobů, jak účinnost léčby zvýšit. Studie naznačují, že roli může hrát například složení střevní mikroflóry nebo strava bohatá na vlákninu. Vliv mohou mít i některé běžně užívané léky snižující cholesterol či načasování podání léčby během dne. Podle výzkumníků pomáhá i kombinace imunoterapie s dalšími způsoby léčby rakoviny.
Léčba pro konkrétního člověka
Velkou naději vědci spojují také s personalizovanou medicínou. Různé nádory mají odlišné genetické vlastnosti, a proto na léčbu reagují rozdílně. „Rakovina není jedno onemocnění. Je to asi 200 odlišných nemocí a všechny vznikají z jiných důvodů a musí být léčeny individuálně,“ sdělila Knudsenová. I dva pacienti se stejným typem a stadiem rakoviny mohou mít na buněčné úrovni odlišné formy onemocnění.
Vědci zkoumají také možnost očkování proti rakovině. Podle Knudsenové by tyto vakcíny fungovaly podobně jako klasické očkování, místo imunizace by se ale používaly k léčení nemoci. Rakovinné buňky mají na povrchu specifické proteiny a výzkumníci by mohli být schopni pomocí očkování naučit imunitní systém pacienta, aby je rozpoznal a zacílil na ně. BBC ale doplňuje, že vývoj tohoto typu léčiv čeká ještě dlouhá cesta.